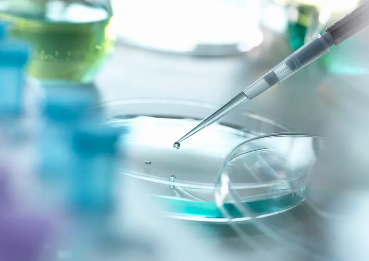
image.png

深圳干細(xì)胞排名前十哪家最受歡迎?患者真實評價。
2024-10-24 12:06:48 來源: 小編 咨詢醫(yī)生
本文將深入探討深圳干細(xì)胞治療領(lǐng)域的排名情況,以及患者的真實評價,為有需要的朋友們提供參考。
在近年來,干細(xì)胞治療作為一種前沿的生物技術(shù),在我國得到了廣泛的應(yīng)用和發(fā)展。深圳作為我國的一線城市,擁有眾多知名的干細(xì)胞治療機(jī)構(gòu)。那么,在這些排名前十的干細(xì)胞治療機(jī)構(gòu)中,哪家最受歡迎呢?
接下來,我們通過患者的真實評價來一探究竟。
1.深圳市某醫(yī)院干細(xì)胞治療中心
該中心擁有一流的專家團(tuán)隊和先進(jìn)的設(shè)備,致力于干細(xì)胞治療研究多年?;颊咴u價:中心的服務(wù)態(tài)度非常好,專家團(tuán)隊的診療水平高超,治療過程中耐心解答疑問。但部分患者表示,價格相對較高。
2.深圳市某生物科技有限公司
該公司專注于干細(xì)胞治療技術(shù)的研究和應(yīng)用,擁有多項專利?;颊咴u價:治療效果較好,工作人員熱情周到,但部分患者反映,治療費用較高,且預(yù)約難度較大。
3.深圳市某生物科技有限公司
該公司在干細(xì)胞治療領(lǐng)域具有較高的知名度,擁有豐富的臨床經(jīng)驗?;颊咴u價:專家團(tuán)隊專業(yè),治療效果顯著,但部分患者表示,價格稍高,且治療周期較長。
4.深圳市某醫(yī)院干細(xì)胞治療中心
該中心擁有一支實力雄厚的專家團(tuán)隊,治療技術(shù)成熟?;颊咴u價:中心的服務(wù)態(tài)度和治療水平都很好,但部分患者反映,治療費用較高,且預(yù)約困難。
5.深圳市某醫(yī)院干細(xì)胞治療中心
該中心在干細(xì)胞治療領(lǐng)域具有較高的聲譽,擁有一流的專家團(tuán)隊?;颊咴u價:治療效果明顯,服務(wù)態(tài)度好,但部分患者表示,價格較高,且治療周期較長。
6.深圳市某生物科技有限公司
該公司致力于干細(xì)胞治療技術(shù)的研究與應(yīng)用,擁有多項專利?;颊咴u價:治療效果較好,工作人員熱情周到,但部分患者反映,治療費用較高。
7.深圳市某醫(yī)院干細(xì)胞治療中心
該中心在干細(xì)胞治療領(lǐng)域具有較高的知名度,治療技術(shù)成熟。患者評價:專家團(tuán)隊專業(yè),治療效果顯著,但部分患者表示,價格較高。
8.深圳市某醫(yī)院干細(xì)胞治療中心
該中心擁有一支實力雄厚的專家團(tuán)隊,治療技術(shù)成熟?;颊咴u價:治療效果較好,服務(wù)態(tài)度好,但部分患者反映,價格較高。
9.深圳市某生物科技有限公司
該公司在干細(xì)胞治療領(lǐng)域具有較高的知名度,擁有豐富的臨床經(jīng)驗?;颊咴u價:治療效果明顯,工作人員熱情周到,但部分患者表示,治療費用較高。
10.深圳市某醫(yī)院干細(xì)胞治療中心
該中心擁有一流的專家團(tuán)隊和先進(jìn)的設(shè)備,致力于干細(xì)胞治療研究?;颊咴u價:中心的服務(wù)態(tài)度和治療水平都很好,但部分患者反映,價格較高。
綜合以上患者的真實評價,我們可以發(fā)現(xiàn),深圳干細(xì)胞排名前十的機(jī)構(gòu)中,最受歡迎的當(dāng)屬深圳市某醫(yī)院干細(xì)胞治療中心。該中心在治療效果、服務(wù)態(tài)度等方面得到了患者的高度評價。然而,需要注意的是,每個患者的需求和病情不同,選擇干細(xì)胞治療機(jī)構(gòu)時應(yīng)綜合考慮自身實際情況。希望本文能為廣大患者提供有益的參考。
- 2024-11-01干細(xì)胞的分泌過程是怎樣的?有哪些關(guān)鍵步驟?
- 2024-10-14干細(xì)胞超低溫樣本庫價格
- 2024-11-12干細(xì)胞治療腎衰竭有哪些優(yōu)勢,患者需要注意哪些事項
- 2024-10-15干細(xì)胞技術(shù)
- 2024-11-04干細(xì)胞美容有哪些顯著功效與作用?
- 2024-07-31干細(xì)胞技術(shù)最新消息,干細(xì)胞國內(nèi)技術(shù)成熟嗎
- 2024-09-11抗衰老干細(xì)胞怎樣提取,從哪里提取
- 2024-09-02干細(xì)胞治療成功治愈率高嗎,干細(xì)胞治療疾病徹底嗎
- 2024-07-17臍帶干細(xì)胞有必要存嗎,儲存的價格及作用介紹
- 2024-09-19造血干細(xì)胞移植后食譜,收好這份飲食指南
- 2024-09-13蘋果干細(xì)胞原液的作用與功效和注意事項
- 2024-07-24干細(xì)胞存儲費用,干細(xì)胞存儲的意義是什么
- 2024-10-11干細(xì)胞與傳統(tǒng)治療有何區(qū)別?未來治療前景如何?
- 2024-10-10重慶干細(xì)胞移植費用高嗎?影響因素解析
- 2024-09-12怎樣選擇干細(xì)胞儲存機(jī)構(gòu),這五點至關(guān)重要
- 2024-09-04海南干細(xì)胞機(jī)構(gòu)有多少家,海南干細(xì)胞公司排名前十
- 2024-09-27廣州市貝拉國際醫(yī)療
- 2024-09-13國內(nèi)知名干細(xì)胞存儲公司排名榜單
